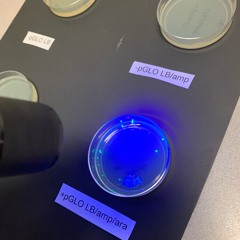
Colony

XaeboR - Glocks
CSGOD
23.6K
4:06
Jan 16, 2017
1029
14
207
iTunes: apple.co/2jvkv77
Spotify: bit.ly/2jezp0y
Beatport: btprt.dj/2jVHwzZ
@xaebor
twitter.com/XaeboR
www.facebook.com/XaeboR
@csgordie
twitter.com/csgordie
www.facebook.com/csgordie
Artwork by Scott Neilson
Recent comments
Half of Nothing
· 7yThats the stuff!
Sentinel
· 8ymean flow <3
redshifts.
· 8yhot damn bro
m3gadeth
· 8ytuuubes!!






![Digitist - Hex Drone [Oolacile Remix] (CLIP)](https://i1.sndcdn.com/artworks-000167175693-jrj2yq-t240x240.jpg)